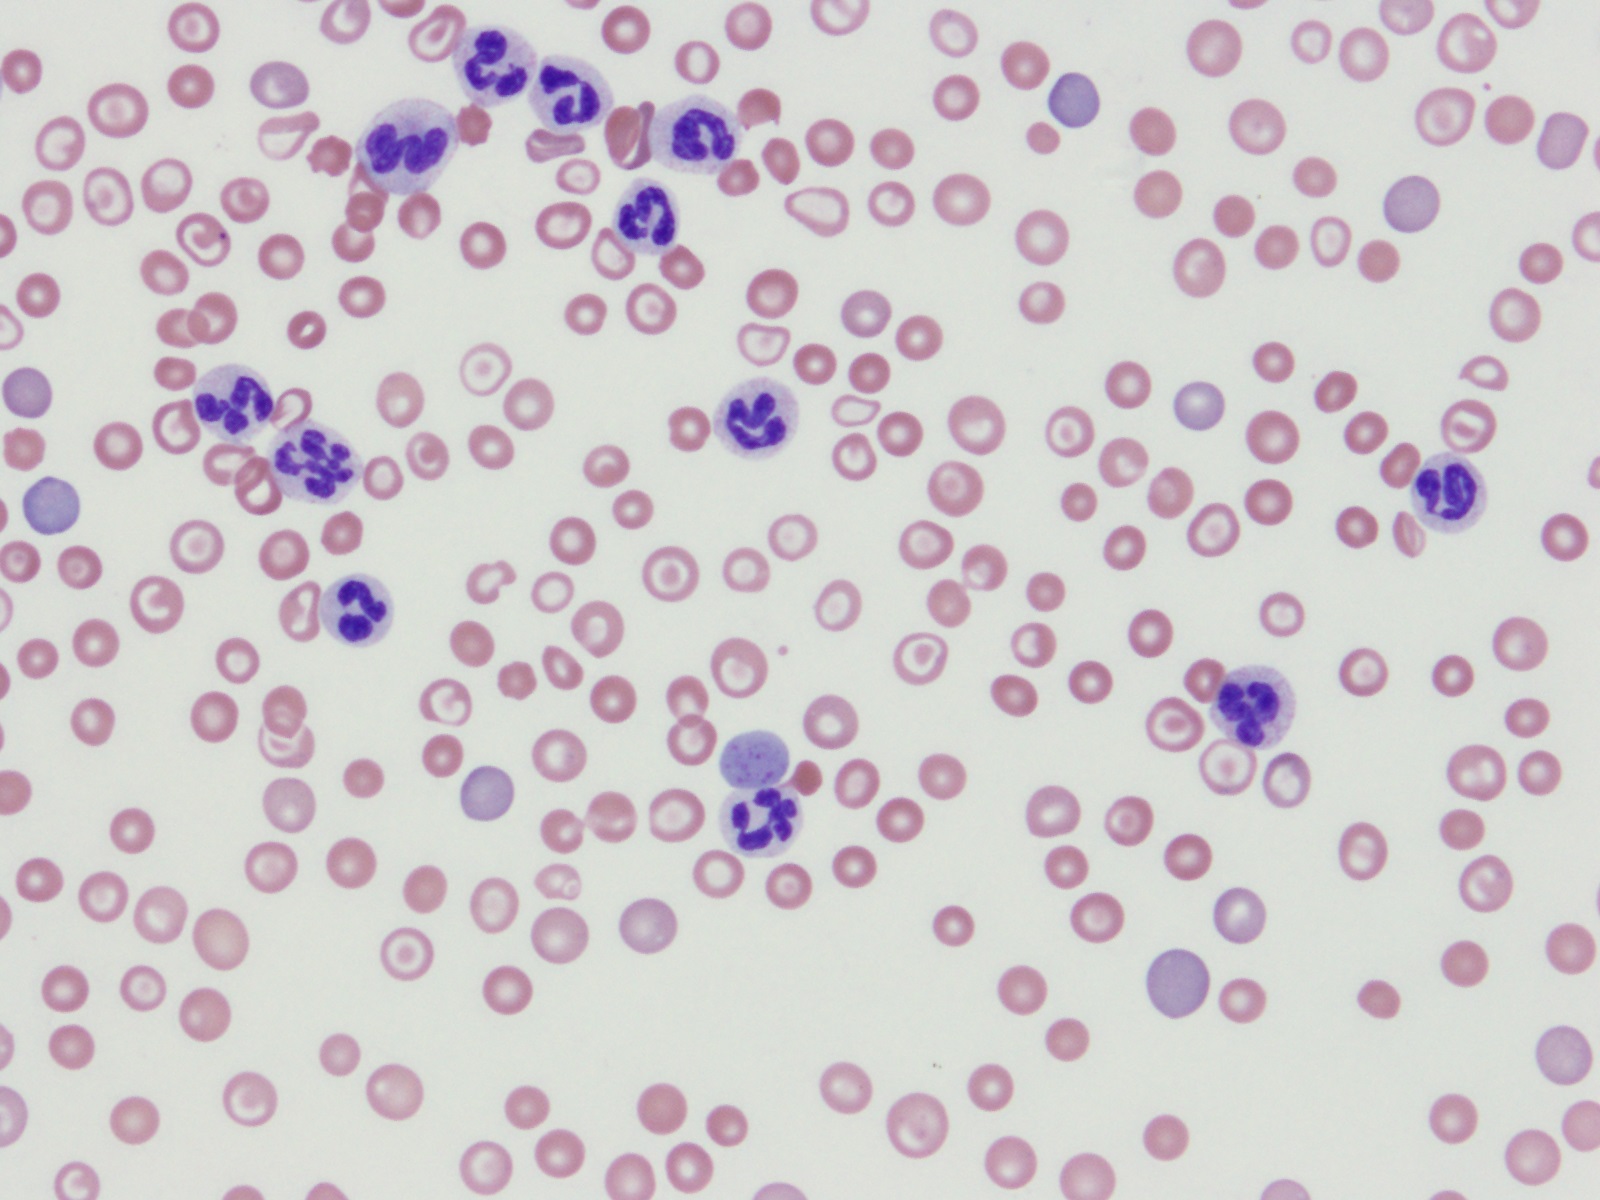

Manuels de laboratoire
Les manuels de laboratoire suivants sont des documents de référence qui fournissent des renseignements techniques sur les différents tests de laboratoire effectués par les Services de diagnostic vétérinaire (SDV). (Les manuels de laboratoire disponible en anglais seulement)
Nous joindre
Services de diagnostic vétérinaire
545 University Crescent,
Winnipeg, Manitoba R3T 5S6
Téléphone : 204-945-8220 in Winnipeg
Courriel : vetlab@gov.mb.ca